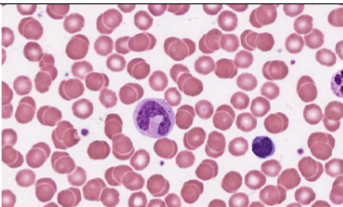

Tissue identification- Nelson fall 2025
1/14
There's no tags or description
Looks like no tags are added yet.
Name | Mastery | Learn | Test | Matching | Spaced |
|---|
No study sessions yet.
15 Terms

Areolar tissue
Location: Papillary dermis, under epithelia
Function: Cushion, diffusion, immunity
Key features of ID: Loose mesh with all fibers and many cell types

Areolar tissue
Location: Papillary dermis, under epithelia
Function: Cushion, diffusion, immunity
Key features of ID: Loose mesh with all fibers and many cell types

Dense irregular connective tissue
Location: Reticular dermis, organ capsules
Function: Resists tension in multiple directions
Key features of ID: Swirled mess of collagen fibers, few cells

Dense regular connective tissue
Location: tendons and ligaments
Function: Resists tension in one direction
Key features of ID: Aligned wavy fibers, one direction, few cells (fewer nuclei than skeletal muscle).

Hyaline cartilage
Location: Trachea, tip of nose, costal cartilage, articular surfaces
Function: Support with flexibility
Key features of ID: Glassy, pale matrix, Chondrocytes in lacunae, few visible fibers

Fibrocartilage
Location: Vertebral discs, pubic symphysis, menisci, transition from tendon to bone
Function: Strong shock absorption
Key features of ID: Thick collagen bundles in rows with chodrocytes

Elastic cartilage
Location: external ear, epiglottis
Function: Flexible support, recoil
Key features of ID: Chondrocytes in lacunae and dark elastic fibers

Compact bone
Location: Skeleton
Function: Support, protection, calcim homeostasis
Key features of ID: Osteons
Blood
Location: In blood vessels
Function: Transport gases, nutrients, waste, and immune cells
Key features of ID: Fluid matrix with RBCs and some WBCs

Adipose tissue
Location: Hypodermis, abdomen, breasts, around kidneys
Function: Energy storage, heat retention
Key features of ID: Large, clear fat vacuolesthe , peripherial nuclei.

Reticular connective tissue
Location: Lymph nodes, spleen, bone marrow
Function: Structure and support around cells
Key features of ID: Branched fiber structure

Skeletal muscle
Location: Attached to bones
Function: Movement, posture, heat
Key features of ID: Striations or dots, nuclei on the periphery, multinucleated.

Cardiac muscle
Location: Heart
Function: Pump blood
Key features of ID: Central nuclei, one nucleus, and Intercalated discs.

Smooth muscle
Location: Organs, arterioles
Function: Movement of substances, regulates diameter
Key features of ID: One nuclei, spindle-shaped

Nervous
Location: Brain, spinal cord, nerves
Function: Communication, control, support
Key features of ID: Dendrites and axons on neuron, smaller glia are all around